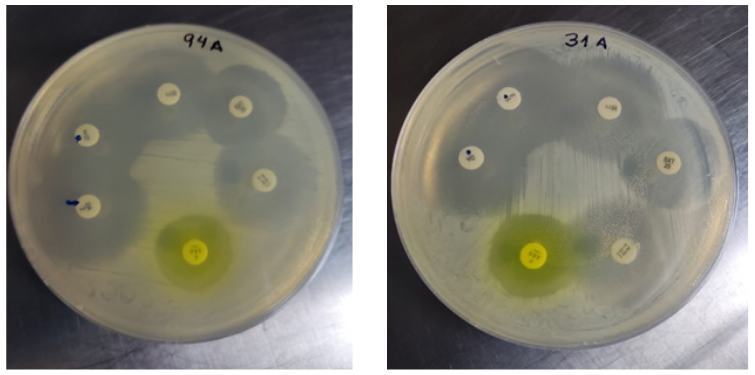
D-test positivo
muestras SARM, formaci&oacute;n de la D en los discos de clindamicina
frente al de eritromicina

Artículos
Vigilancia epidemiológica de Staphylococcus aureus y resistencia antibiótica en ambientes nosocomiales
Revista de Investigación en Salud VIVE
Centro de Estudios Transdisciplinarios, Bolivia
ISSN: 2664-3243
ISSN-e: 2664-3243
Periodicidad: Cuatrimestral
vol. 5, núm. 13, 2022
Recepción: 14 Marzo 2022
Aprobación: 11 Abril 2022
Publicación: 27 Mayo 2022

Resumen: Uno de los microrganismos más importantes en Infecciones Asociadas a la Atención en Salud (IAAS) es Staphylococcusaureus, una bacteria aerobia Gram positiva, resistente a diferentes condiciones ambientales. Objetivo. Identificar Staphylococcus aureus y su resistencia a los principales antibióticos Betalactámicos, aislada en áreas inertes. Materiales y métodos. Se realizó análisis fenotípico, antibiograma y métodos moleculares como: Extracción de ADN mediante Lisis Alcalina, identificación molecular para la amplificación de los genes tanto de identificación de la bacteria (nucA y femB), como de resistencia de antibióticos (blaZ, mecA y vanA) mediante PCR punto final, la separación de los amplicones se realizó mediante electroforesis en gel de Agarosa, los productos de la PCR se revelaron mediante la utilización de transiluminador UV. Resultados. De 200 muestras tomadas se obtuvo dos muestras positivas (1%) para Staphylococcus aureus, con el 100% de resistencia a penicilina y sensible a todos los demás antibióticos testeados. Conclusiones. La identificación de la bacteria y su resistencia hoy en día se realiza mayormente mediante métodos moleculares, lo cual no descarta la identificación fenotípica que, en este caso, determinó resultados importantes como lo es la prueba D-test positivo. La resistencia a fármacos betalactámicos se considera como un serio problema de salud, por lo tanto, se requiere de una vigilancia epidemiológica constante.
Palabras clave: Staphylococcus aureus, IAAS, nucA, femB, blaZ, mecA, vanA, Genes, electroforesis, Reacción en Cadena de la Polimerasa.
Abstract: Staphylococcus aureus is one of the most important microorganisms related to Health Care Associated Infections (HCAI), it is a Gram-positive aerobic bacterium, highly resistant to the outer environment. Objective. Identify Staphylococcus aureus and its resistance to the most common beta-lactam antibiotics in isolated, inert areas. Materials and methods. Phenotypic analysis, antibiogram and molecular testing such as: DNA extraction by Alkaline Lysis, molecular identification for the amplification of genes both for identification of Staphylococcus aureus (nucA and femB), and for antibiotic resistance (blah, mega and vanA) by PCR, the disassociation of the amplicons was preforming by Agarose gel electrophoresis and results were shown in a UV translluminator. Results. From the 200 samples taken, two showed positive (1%) for Staphylococcus aureus, with 100% penicillin-resistant and sensitive to all other antibiotics tested. Conclusions. Nowadays identification of the bacteria and its resistance is carried out mostly through molecular testing, ruling out phenotypic identification, which in this case it determined important results such as the positive D-test. Resistance to beta-lactam drugs is considered a serious health issue, therefore it requires a safer epidemiological vigilance, an increase in sensitivity testing and the accuracy of results. It is recommended to carry out the D-test in laboratories to identify resistance mechanisms and to guide health personnel to select the best option regarding specific and effective treatment for patients affected with MRSA.
Keywords: Staphylococcus aureus, IAAS, nucA, femB, blaZ, mecA, vanA, genes, electrophoresis, Polymerase Chain Reaction.
Resumo: Um dos microrganismos mais importantes em Infecções Associadas à Saúde (HAIs) é o Staphylococcus aureus, uma bactéria aeróbica gram-positiva resistente a diferentes condições ambientais. Objetivo. Identificar Staphylococcusaureus e sua resistência aos principais antibióticos betalactam, isolados em áreas inertes. Materiais e métodos. Análise fenotípica, antibiograma e métodos moleculares foram realizados tais como: extração de DNA por Alkaline Lysis, identificação molecular para a amplificação dos genes tanto da identificação da bactéria (nucA e femB), e resistência a antibióticos (blaZ, mecA e vanA) pelo ponto final da PCR, a separação dos amplicons foi realizada por eletrofose em gel de Agarose, os produtos PCR foram revelados usando transiluminador UV. Resultados. De 200 amostras colhidas, duas amostras positivas (1%) foram obtidas para o Staphylococcus aureus, com 100% de resistência à penicilina e sensível a todos os outros antibióticos testados. Conclusões. A identificação da bactéria e sua resistência hoje é realizada principalmente por métodos moleculares, o que não exclui a identificação fenotípica que, neste caso, determinou resultados importantes como o teste D positivo. A resistência aos medicamentos betalactam é considerada um grave problema de saúde, portanto, é necessária uma vigilância epidemiológica constante.
Palavras-chave: Staphylococcus aureus, IAAS, nuca, femB, blaZ, mecA, vanA, Genes, electrophoresis, Polymerase Chain Reaction.
INTRODUCCIÓN
La Organización Mundial de la Salud define como infección al contacto del paciente con la bacteria y exposición con superficies inertes o pacientes contaminados (1). Las Infecciones Asociadas a la Atención en Salud (IAAS) es uno de los principales motivos de infección a nivel mundial, llevando consigo dificultades tales como el alargamiento de la estancia hospitalaria, importantes perjuicios económicos, morbilidad, discapacidad, y mayor resistencia microbiana (2,3).
En Ecuador se implementó desde el año 2018, a través del Subsistema de vigilancia epidemiológica para las Infecciones Asociadas a la Atención en Salud (IAAS), el control de dichas infecciones, dando como resultados tasas altas de contaminación a comparación de países vecinos. Uno de los microrganismos más importantes en las IAAS es Staphylococcus aureus (S. aureus), una bacteria aerobia, Gram positiva, muy resistente y que se adapta a condiciones ambientales y sobre todos hospitalarias, capaz de colonizar superficies inertes (4,5). La identificación de esta bacteria se realiza por medio de métodos fenotípicos y moleculares, el método molecular se basa en la amplificación de los genes nucA que codifican a enzimas como la termonucleasa que es producida por casi todas las cepas de S. aureus y femB importante componente de la pared celular de esta bacteria (6,7).
Los antibióticos más usados para contrarrestar las infecciones por S. aureus son la Penicilina y Metilciclina, pero el mal uso de estos ha provocado que actualmente muchas sepas sean resistentes a Meticilina y más del 90 % de cepas resistentes a Penicilina, estas resistencias se encuentran codificadas por los genes mecA (PBP2a) y blaZ (betalactamasa) respectivamente (8,9).
Si bien se han realizado varios estudios de Staphyloccoccus aureus como factor importante de las IAAS y sobre todo como microorganismo resistente a betalactámicos, en la ciudad de Cuenca-Ecuador existen pocas referencias específicas sobre los genes que codifican la resistencia a estos antibióticos en aislados en zonas inertes.
El objetivo de la presente investigación es identificar Staphylococcus aureus y su resistencia a betalactámicos en áreas inertes en una clínica privada de la ciudad Cuenca en el periodo 2021, mediante análisis microbiológico y molecular
MATERIALES Y MÉTODOS
Se realizó un estudio observacional, de corte transversal. Se usó un muestreo de tipo no probabilístico por cobertura total de superficies inertes de una clínica privada en la ciudad de Cuenca-Ecuador, excluyendo áreas de menor contacto del paciente como recepción y área administrativa e incluyendo áreas críticas de mayor riesgo de contagio y mayor contacto como: emergencia, pasillos, sala de espera, quirófano, área de recuperación y hospitalización; cada una de ellas en sitios específicos como interruptores, manijas de baños y puertas, dispensadores de gel-jabón, mesas, camillas, roperos, botones de maquinarias de salud, manijas de inodoros y lavadores. En total se recolectaron 200 muestras comprendidas entre: 40 muestras en emergencia, 55 muestras en hospitalización 1er piso, 33 en hospitalización 2do piso, 25 muestras en quirófano, 32 muestras en sala de parto, 15 en recuperación, al ser superficies inertes se obtuvo autorización del gerente general de la clínica para proceder con el estudio, la toma de muestra en la clínica fue de imprevisto para evitar desinfecciones excesivas y obtener resultados más reales
Toma de muestra
Las muestras se obtuvieron mediante la técnica de hisopo estéril en superficies inertes según las normas INEN– Ecuador, (4) mismos que fueron embebidos en caldo Trypticasa soya en tubos tapa rosca y trasladados al Laboratorio de Genética y Biología Molecular del Centro de Investigación, Innovación y Transferencia de Tecnología de la Universidad Católica de Cuenca transcurrida una hora
Análisis Fenotípico
Se realizó la siembra de las muestras en las pruebas fenotípicas más comunes para identificación de S. aureus, en primer lugar, se procedió con la siembra de las muestras en agar Manitol Salado, una vez que se presentó el crecimiento bacteriano en este medio se procedió con las siguientes pruebas microbiológicas: tinción de GRAM, coagulasa, DNAsa (10). El antibiograma se realizó en medio de Mueller Hinton y su sensibilidad antibiótica con interpretación en base al CLSI, 2021 (11)
D-test
En un cultivo de S. aureus, se coloca un disco antibiótico de clindamicina y otro de eritromicina con más o menos 15 – 20 mm de distancia formando luego de 24 horas de incubación una D en aquellas cepas con resistencia inducible a clindamicina del lugar en donde se encuentra el disco de eritromicina presentando una resistencia inducible a clindamicina (12)
Análisis molecular


La extracción de ADN se realizó mediante el método de lisis alcalina con Sodio Dodecilsulfato (SDS) al 1% en NaOH al 0,25N (13). La identificación molecular se realizó mediante reacción en cadena de la polimerasa (PCR, por sus siglas en inglés) punto final en un termociclador Bioneer, con protocolos específicos tanto para la determinación de los genes para identificación de la bacteria nucA y femB (tabla1), como para resistencia de antibióticos de la misma blaZ, mecA y vanA (Tabla 2) mediante (14) . La separación de los amplicones productos de la PCR se realizó mediante electroforesis en gel de Agarosa y el resultado se reveló en un transiluminador UV y se documentó con una cámara digital con el siguiente protocolo de amplificación: (13). [Ver Tabla 1]
La presente investigación se realizó bajo las estrictas normas de higiene y desechos de material nocivo de casas de salud, sin afectar el correcto funcionamiento de la institución y sus pacientes (15)
RESULTADOS Y DISCUSIÓN

Se identificó 2 muestras positivas para S. aureus de las 200 recolectadas: 1 en la perilla de entrada de emergencia a hospitalización y la segunda en la perilla del cajón de almacenamiento de la estación de enfermería (Tabla 3). Cabe recalcar que se realizó diagnóstico fenotípico en donde se tuvo positivo en agar Manitol, Coagulasa y DNAsa positivo en las dos muestras y análisis molecular tanto para identificación de la bacteria como para resistencia
El antibiograma mostró resistencia a penicilina en las dos muestras positivas, y sensibilidad a los demás antibióticos testeados: cefoxitin, gentamicina, tetraciclina, ciprofloxacina, levofloxacina, nitrofurantoina, trimetropin sulfametoxazol, cloranfenicol, rifampicina y vancomicina (Ver Tabla 4).
Se identificó D-Test positivo (Figura1), que refiere a una resistencia inducible a clindamicina por la eritromicina, es decir se visualiza una distorción del halo de inhibición alrededor del disco de clindamicina en la cara que enfrenta al disco de eritromicina (16)

Resultados de las pruebas moleculares
Se confirmó la presencia de la bacteria S. aureus mediante el resultado positivo para amplificación de los genes nucA y femB (Figura 2), propios de la bacteria.

De la misma forma, se obtuvo la amplificación del gen blaZ (Figura 3) como gen responsable de la resistencia a la penicilina (betalactamasas) y confirmado con antibiograma Mueller Hinton (resultados anteriores); además se obtuvieron resultados negativos para amplificación de los genes mecA y vanA (fig3), que inducen a la resistencia a la metilcilina y vancomicina respectivamente

Discusión
Staphylococcus aureus resistente a la metilcilina (SARM) afecta a niños, jóvenes y adultos desarrollando Infecciones Asociadas a la Atención en Salud (IASS) de gran importancia (17,18). La bacteria en estudio, S. aureus, fue analizada en base a las características que posee para colonizar en zonas hospitalarias a temperaturas que oscilan de 30 a 37°C (3). Por lo tanto, S. aureus, es considerado uno de los principales patógenos intrahospitalarios, mismo que se ha podido hallar en zonas inertes como superficies y dispositivos hospitalarios.
En el presente estudio se obtuvo una incidencia baja (1% 2/200) con un 100% de resistencia a penicilina y sensible a antibióticos como cefoxitin, gentamicina, tetraciclina, trimetropin sulfametoxazol. Los resultados obtenidos y comprobados mediante diagnóstico fenotípico y molecular dan como positiva la primera muestra para la bacteria en la perilla de la puerta de entrada de emergencia al hospital y la segunda muestra en la perilla del cajón de almacenamiento del área de estancia de enfermería. Se encontraron resultados similares en un estudio realizado por San Martin, Andrade y Orellana con 6 cepas aisladas de S. aureus de 200 muestras recogidas con 100% de resistencia a penicilina y sensibilidad a antibióticos como: trimetoprim sulfametoxazol, rifampicina, etc., además coinciden que la zona en la que se aisló la bacteria fue en Emergencia (19).
Un estudio de Medina, Andrade y Orellana, sobre Detección de Staphylococcus aureus en pantallas de celulares mostró como resultados un 17,39% (16/92) positivo para S. aureus, el cual ya genera un porcentaje mayor a los anteriores de crecimiento (20). Del mismo modo en Mohammedia, Moroco se encuentra que el 48,5% de las bacterias aisladas fueron S. aureus, 87,5% encontradas en el área de emergencia, con una resistencia del 90,3% a ampicilina y sensibilidad a imipenem, teniendo características semejantes al estudio realizado, (21). Igualmente, un estudio sobre Contaminación bacteriana de los teléfonos móviles de los trabajadores de la salud en Uganda arroga resultados de un 61,11% de resultados positivos para Staphylococcus sin especificar la especie, con un 90% de resistencia a penicilina y sensibles a gentamicina (22).
En el Hospital Regional de ICA-Perú de Leveau-Bartra Harry, un análisis bacteriológico de superficies inertes y sensibilidad antibiótica en el servicio de cirugía general, tiene como resultado a S. aureus como una de las bacterias encontradas en el estudio, en el servicio de cirugía–quirófano con resistencia a penicilina, (23). Asimismo, se realiza también en la Universidad de Carabobo-Venezuela, una Evaluación microbiológica de aire y superficies en quirófano de un centro de salud público por Noja Izzeddin, en donde se puede identificar un 15% de frecuencia para S. aureus en el área de quirófano, (24). Se da el caso también de un estudio de resistencia de Cepas de S. aureus aislados en ambientes nosocomiales por Vallejo, Orellana y Andadre que dan resultados similares al presente proyecto con un 3% de positivo para la bacteria en Cuenca Ecuador (25).
En los estudios analizados (18–20,21,23- 25) se encuentran zonas inertes susceptibles para crecimiento bacteriano tales como mesas, camillas, perillas de puertas, celulares, siendo estos los principales conductores de Infecciones Asociadas a la Atención en Salud. Dado es el caso que la baja incidencia de Staphylococcus aureus encontrada en el presente estudio, puede deberse a que la clínica en donde se tomaron las muestras, cumple por ordenamiento con normas de higiene y seguridad implementadas por el INEN y el ARCSA regímenes de control sanitario. Al igual que los cuidados extremos que las casas de salud adoptan debido a la pandemia por Covid-19 que estamos atravesando, factores que influyen a que se disminuya la propagación de dicha bacteria. En el presente proyecto, se obtuvo también resultados positivos para D-test en las dos muestras ya analizadas de S. aureus, corroborando una resistencia inducible a clindamicina por la Eritromicina en un 100%. Se compara dichos resultados con los de un estudio por Castellano y Perozo en la Universidad de Zulia Venezuela en donde se obtuvo resultados de un 31,43% de resistencia constitutiva e inducida (12). Tal cual un estudio en Paraguay sobre la misma resistencia inducible a clindamicina en Staphylococcus aureus resistente a metilcilina, en donde de la cantidad total aislada el 11% es atribuible al mecanismo de resistencia a clindamicina inducible, lo que afirma la presencia de la resistencia propiamente dicha (26).
En Chile, en el hospital Luis Calvo Makena, por Montoya y Mira O. de las 155 muestras, el 43,8% resultados positivos a la resistencia (27). De forma semejante se realiza un estudio en Irán por Azadi Faezi, y Alka Hasani con resultados de un12% de aislamientos con D-test positivo (28). Por otra parte, es importante mencionar que no se encuentran estudios realizados específicamente en Cuenca-Ecuador sobre el D-test, siendo importante seguir investigando si es que se hace esta prueba en los laboratorios para identificación de resistencia antibiótica inducida en esta ciudad. Por lo tanto, los estudios encontrados sobre D-test, coinciden en la presencia de la resistencia inducible a clindamicina, un problema de salud que afecta a pacientes que podrían presentar sensibilidad o resistencia a antibióticos determinados y no tener éxito en su tratamiento
CONCLUSIONES
Staphylococcus aureus es una de las bacterias de mayor incidencia en superficies inertes en casas de salud, causando serias complicaciones como Infecciones Asociadas a la Atención en Salud y, debido a la resistencia a antibióticos que complica aún más la estancia del paciente.
La identificación de la bacteria y su resistencia hoy en día se realiza mayormente de forma molecular (PCR), descartando identificación fenotípica que, en este caso, se determinaron resultados importantes como la prueba D-test positivo en las dos muestras aisladas de S. aureus del presente proyecto. En este sentido, es importante identificar la resistencia inducible a clindamicina mediante la formación de una D diferente al halo que comúnmente se ve en el antibiograma, resultados que no se podrían obtener mediante PCR, puesto que las amplificaciones de genes serían solamente resultados complementarios.
En base a los resultados obtenidos se pudo demostrar que, la resistencia a fármacos betalactámicos constituye un serio problema de salud, por lo tanto, se requiere de una vigilancia epidemiológica más segura, más sensibilidad en las pruebas realizadas y resultados más precisos.
Se recomienda realizar de forma rutinaria la prueba D-test para identificar mecanismos de resistencia específicos y orientar al personal de salud a tomar la mejor decisión sobre el tratamiento específico y eficaz para el paciente afectado con SARM
REFERENCIAS BIBLIOGRÁFICAS
1. Girard R, Perraud M, Herriot HE, Prüss A. y Savey A. Prevention of hospital-acquired infections - WORLD HEALTH ORGANIZATION. World Health Organ [Internet]. diciembre de 2002; 2nd edition (Department of Communicable Disease, Surveillance and Response):72. Disponible en: http://www.who. int/emc
2. Álvarez Lerma F, Palomar M, Insausti J, Olaechea P, Cerdá E, Sánchez Godoy J, et al. Infecciones nosocomiales por Staphylococcus aureus en pacientes críticos en unidades de cuidados intensivos. Med Clínica [Internet]. mayo de 2006 [citado 12 de diciembre de 2021];126(17):641-6. Disponible en: https://linkinghub.elsevier.com/retrieve/pii/ S0025775306720450
3. Inweregbu K, Dave J. y Pittard A. Nosocomial infections. Contin Educ Anaesth Crit Care Pain [Internet]. 1 de febrero de 2005 [citado 19 de febrero de 2022];5(1):14-7. Disponible en: https://doi.org/10.1093/bjaceaccp/mki006
4. González Herrera SL, Lozada Méndez M. y Santiago Roque I. Análisis bacteriológico de superficies inertes. Rev Cuba Hig Epidemiol [Internet]. diciembre de 2014 [citado 4 de diciembre de 2021];52(3):314-20. Disponible en: http://scielo.sld.cu/scielo.php?script=sci_ abstract&pid=S1561-30032014000300004&ln g=es&nrm=iso&tlng=es
5. Stewart GC. Staphylococcus aureus. Foodborne Pathog Microbiol Mol Biol [Internet]. 2005 [citado 19 de febrero de 2022];273-84. Disponible en: https://www.cabdirect.org/ cabdirect/abstract/20063045985
6. Laica SP, Andrade CF. y Orellana PP. Resistance to beta-lactams in Staphylococcus aureus isolated from cell phone screens of dentistry students based on an antibiogram and detection of blaZ and mecA genes [Internet]. GMR | Genetics and Molecular Research | The Original by FUNPEC-RP. 2021 [citado 27 de marzo de 2022]. Disponible en: https:// www.geneticsmr.com/articles/resistance-betalactams- staphylococcus-aureus-isolated-cellphone- screens-dentistry
7. Pacheco MA, Orellana PP. y Andrade CF. Virulence genes in Staphylococcus aureus isolated from cell phone screens of dentistry students in Cuenca-Ecuador [Internet]. GMR | Genetics and Molecular Research | The Original by FUNPEC-RP. 2021 [citado 16 de marzo de 2022]. Disponible en: https://www. geneticsmr.com/articles/virulence-genesstaphylococcus- aureus-isolated-cell-phonescreens- dentistry-students-cuenca
8. Castellano González MJ, y Perozo-Mena AJ. Mecanismos de resistencia a antibióticos β-lactámicos en Staphylococcus aureus. Kasmera [Internet]. junio de 2010 [citado 12 de diciembre de 2021];38(1):18-35. Disponible en: https://n9.cl/zyh3m
9. Simor AE, Ofner-Agostini M, Bryce E, Green K, McGeer A, Mulvey M, et al. The evolution of methicillin-resistant Staphylococcus aureus in Canadian hospitals: 5 years of national surveillance. CMAJ [Internet]. 10 de julio de 2001 [citado 19 de febrero de 2022];165(1):21- 6. Disponible en: https://www.cmaj.ca/ content/165/1/21
10. Dahiya RS, y Speck ML. Hydrogen Peroxide Formation by Lactobacilli and Its Effect on Staphylococcus aureus1. J Dairy Sci [Internet]. 1 de octubre de 1968 [citado 19 de febrero de 2022];51(10):1568-72. Disponible en: https://www.sciencedirect.com/science/ article/pii/S0022030268872327
11. Hindler JA, Clinical and Laboratory Standards Institute. Analysis and presentation of cumulative antimicrobial susceptibility test data. 2022.
12. Castellano González MJ, Perozo Mena AJ, Molero Cubillán M de J, Montero Araujo S del C. y Primera Rodríguez FJ. Resistencia a la clindamicina inducida por eritromicina en cepas de Staphylococcus aureus de origen clínico. Kasmera [Internet]. junio de 2015 [citado 19 de marzo de 2022];43(1):34-45. Disponible en: http://ve.scielo.org/scielo.php?script=sci_ abstract&pid=S0075-52222015000100004&ln g=es&nrm=iso&tlng=es
13. Orbe MLS, Tacuri CFA. y Bravo PPO. Susceptibilidad de cepas de S. aureus aisladas en superficies hospitalarias. Rev Vive [Internet]. 4 de mayo de 2021 [citado 16 de diciembre de 2021];4(11):345-57. Disponible en: http://revistavive.org/index.php/revistavive/ article/view/115
14. Andrade CF. y Orellana PP. Frecuencia y susceptibilidad a penicilina y meticilina de aislamientos ambientales de Staphylococcus aureus en un hospital de Cuenca. Kasmera [Internet]. 2019 [citado 12 de diciembre de 2021];47(2):123-30. Disponible en: https://www. redalyc.org/jatsRepo/3730/373063318007/ html/index.html
15.Acuerdo-Ministerial-323_Reglamentop a r a - l a - g e s t i ó n - i n t e g r a l - d e - l o s - residuos-y-desechos-generados-en-losestablecimientos- de-salud.pdf [Internet]. [citado 22 de diciembre de 2021]. Disponible en: https://n9.cl/9j15p
16. Montoya C I, Mira O M, Álvarez A I, Cofre G J, Cohen V J, Donoso W G, et al. Resistencia inducible a clindamicina en Staphylococcus aureus meticilino resistente. Rev Chil Pediatría [Internet]. febrero de 2009 [citado 18 de marzo de 2022];80(1):48-53. Disponible en: http://www.scielo.cl/scielo.php?script=sci_ abstract&pid=S0370-41062009000100006&ln g=es&nrm=iso&tlng=es
17. Monroy TB, Maldonado VM, Martínez FF, Barrios BA, y Vargas LOS. Candida albicans, Staphylococcus aureus and Streptococcus mutans colonization in patients wearing dental prosthesis. Med Oral Patol Oral Cir Bucal [Internet]. 28 de noviembre de 2004;13. Disponible en: http://www.medicinaoral.com/ pubmed/medoralv10suppl1_i_p27.pdf
18. Harry L-B, Orison L-B, y Alicia A-A. Análisis bacteriológico de superficies inertes y sensibilidad antibiótica en el Servicio de Cirugía General del Hospital Regional de Ica. Rev Médica Panacea [Internet]. 27 de julio de 2019 [citado 19 de marzo de 2022];8(2). Disponible en: https://revistas.unica.edu.pe/ index.php/panacea/article/view/5
19. Orbe MLS, Tacuri CFA, y Bravo PPO. Susceptibilidad de cepas de S. aureus aisladas en superficies hospitalarias. Rev Vive [Internet]. 4 de mayo de 2021 [citado 18 de marzo de 2022];4(11):345-57. Disponible en: https://revistavive.org/index.php/revistavive/ article/view/115
20. Abad MSM, Andrade C, Orellana P, y Sarmiento P. Detección de Staphylococcus aureus en pantallas de celulares de estudiantes de Odontología mediante PCR. Kasmera [Internet]. 11 de octubre de 2021 [citado 18 de marzo de 2022];49(2): e49236014-e49236014. Disponible en: https://produccioncientificaluz. org/index.php/kasmera/article/view/36014
21. Chaoui L, Mhand R, Mellouki F, y Rhallabi N. Contamination of the Surfaces of a Health Care Environment by Multidrug-Resistant (MDR) Bacteria. Int J Microbiol [Internet]. 29 de noviembre de 2019 [citado 19 de marzo de 2022];2019:1-7. Disponible en: https://www. hindawi.com/journals/ijmicro/2019/3236526/
22. Tusabe F, Kesande M, Amir A, Iannone O, Ayebare RR, y Nanyondo J. Bacterial contamination of healthcare worker’s mobile phones: a case study at two referral hospitals in Uganda. Glob Secur Health Sci Policy [Internet]. 31 de diciembre de 2022 [citado 20 de marzo de 2022];7(1):1-6. Disponible en: https://doi.org/10.1080/23779497.2021.20233 21
23. Subhedar V, Subhedar R, S P, y Jain S. Bacterial Contamination of Mobile Phones of Health Care Workers in A Tertiary Care Hospital. Indian J Appl Res [Internet]. 1 de agosto de 2015;5:732-5. Disponible en: https:// www.tandfonline.com/doi/full/10.1080/237794 97.2021.2023321
24. Izzeddin N, Rodríguez GA, Medina L, y González L. Evaluación microbiológica de aire y superficies en quirófano de un centro de salud público. Salus [Internet]. 2017 [citado 19 de marzo de 2022];21(3):18- 23. Disponible en: https://www.redalyc.org/ journal/3759/375955679005/movil/
25. Vallejo G, Andrade C, Orellana P, y Ortiz J. Resistencia de cepas de Staphylococcus aureus aislados en ambientes nosocomiales. Rev Vive [Internet]. 19 de febrero de 2022 [citado 18 de marzo de 2022];5(13):22-34. Disponible en: https://revistavive.org/index. php/revistavive/article/view/148
26. Silvagni M, Guillén R, Rodríguez F, Espínola C, Grau L, Velázquez G, et al. Resistencia inducible a clindamicina en Staphylococcus aureus resistentes a meticilina aislados de pacientes pediátricos en Paraguay. Rev Chil Infectol [Internet]. agosto de 2019 [citado 26 de marzo de 2022];36(4):455-60. Disponible en: https://n9.cl/1vcr9
27. Montoya C I, Mira O M, Álvarez A I, Cofre G J, Cohen V J, Donoso W G, et al. Resistencia inducible a clindamicina en Staphylococcus aureus meticilino resistente. Rev Chil Pediatría [Internet]. febrero de 2009 [citado 26 de marzo de 2022];80(1):48-53. Disponible en: http://www.scielo.cl/scielo.php?script=sci_ abstract&pid=S0370-41062009000100006&ln g=es&nrm=iso&tlng=es
28. Faezi NA, Hasani A, Soltani E, Valizadeh V, Hasani A, Khabbaz A, et al. Plausible challenges of methicillin and clindamycin resistance detection in Staphylococcus aureus. Gene Rep [Internet]. 1 de septiembre de 2021 [citado 26 de marzo de 2022];24:101179. Disponible en: https://www.sciencedirect.com/ science/article/pii/S2452014421001643

